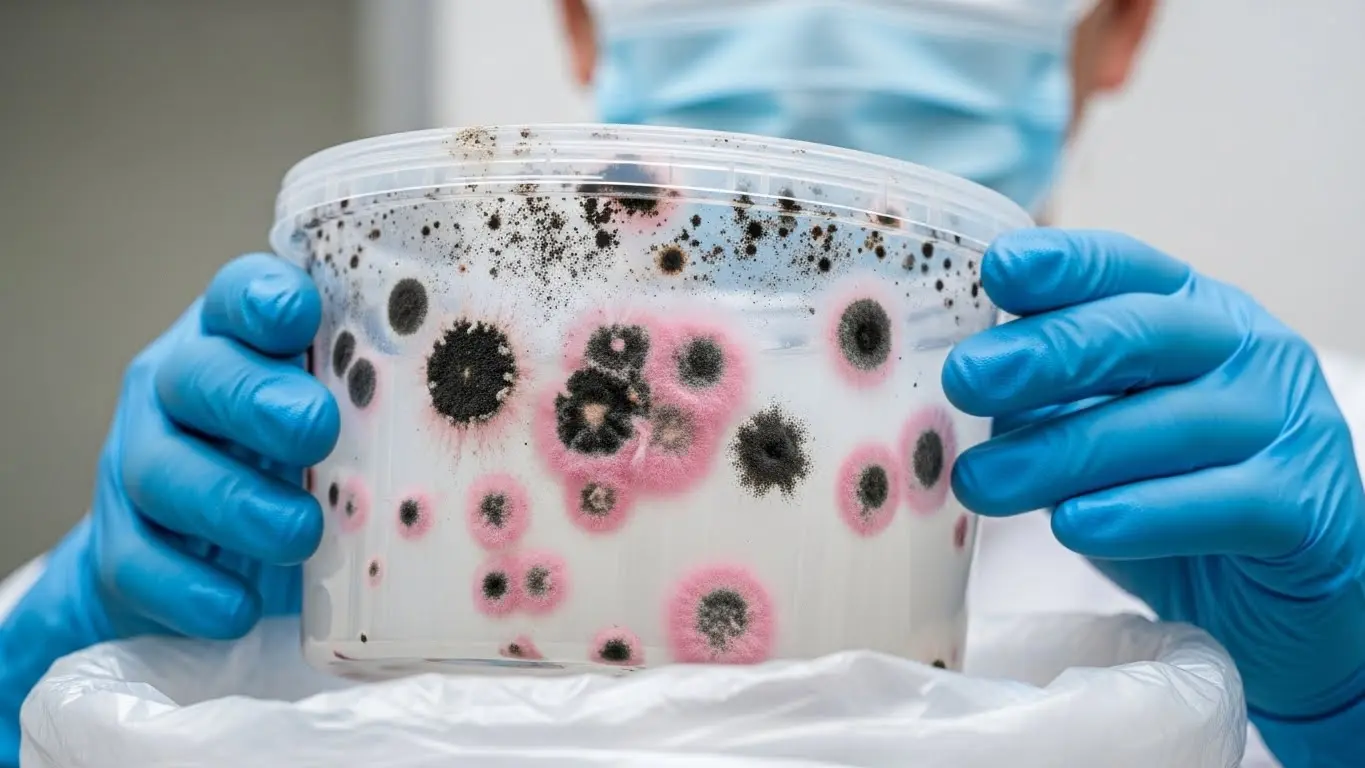

お子様の自由研究や感覚遊びで大人気のダイラタンシー現象。片栗粉と水を混ぜるだけで「握ると固まる、開くと溶ける」という不思議な感触を楽しめる一方で、遊び終わった後の「ドロドロの白い液体」をどう処分すればよいか、頭を抱えていませんか?
「液体だからそのまま流しに捨てても大丈夫?」「それとも固めて捨てるべき?」と迷う方も多いはずです。しかし、実は処分方法を一つ間違えると、ご自宅の排水管を詰まらせる深刻なトラブルに発展する危険性があります。
この記事では、整理収納と家事のプロである私が、ダイラタンシー(片栗粉と水)の安全で正しい捨て方を徹底解説します。排水溝を詰まらせないための具体的な手順から、容器のこびりつき汚れを落とす掃除テクニック、さらにはカビや腐敗などのトラブル対処法まで、2025年12月8日時点の最新情報を踏まえて網羅しました。
この記事を読めば、面倒な後片付けの不安が解消され、次回からも安心してお子様と実験遊びを楽しめるようになりますよ。
この記事のポイント
- ダイラタンシー液を排水溝に直接流すのは厳禁
- 基本は新聞紙などに吸わせて可燃ゴミとして出す
- 大量の場合は沈殿させて水と固形物を分けて処分
- 容器は洗う前に必ず拭き取るのが掃除のコツ
ダイラタンシー現象で作った液体の正しい捨て方と絶対にやってはいけないこと
- 【最重要】排水溝にそのまま流すのは厳禁!配管詰まりの危険性を解説
- 基本の捨て方1:新聞紙や古布に吸わせて可燃ゴミとして出す手順
- 基本の捨て方2:乾燥させて粉末に戻してから処分する方法
- 大量にある場合の対処法と水分と固形物の分離テクニック
- 自治体のゴミ分別ルールにおける片栗粉・コーンスターチの扱い
【最重要】排水溝にそのまま流すのは厳禁!配管詰まりの危険性を解説

ダイラタンシー実験を楽しんだ後、何があっても絶対に避けていただきたいのが「キッチンのシンクや洗面所にそのまま流す」という行為です。これは、私がこれまで数多くのご家庭の片付け相談を受ける中で、最もトラブルになりやすいケースの一つであり、最大級の警告をしたいポイントです。
なぜ流してはいけないのか。その理由はダイラタンシー現象の特性そのものにあります。この液体は、圧力がかかると固まり、圧力がなくなると液体に戻るという特殊な性質(非ニュートン流体)を持っています。
しかし、排水管の中などの「水流が止まった場所」で滞留すると、水に溶けきらない片栗粉(デンプン質)が沈殿し、まるでセメントのように硬く固まってしまうのです。
特に危険なのが、悪臭や害虫の侵入を防ぐために設置されている排水管の「S字カーブ部分(トラップ)」です。ここにデンプンが蓄積すると、通常の水流では押し流すことが困難になり、最悪の場合、完全に管が閉塞して水が逆流する事態を招きます。
「水をたくさん流せば薄まるだろう」と考えるのは非常に危険です。デンプンは水に溶解しているのではなく、粒子として混ざっているだけ(懸濁液)ですので、時間が経てば必ず分離して沈みます。
この沈殿物は非常に粘り気が強く、一度配管の内壁にへばりつくと、市販の強力な液体パイプクリーナーでも簡単には溶けません。もし完全に詰まってしまい修理業者を呼ぶことになると、高圧洗浄や配管の脱着作業などで数万円単位の費用がかかることも珍しくありません。
「流さない」ことが、家計と設備を守る最大の防御策なのです。まずはこの大原則を心に刻んでください。
- 理由: デンプンが沈殿し、セメント状に硬化するため。
- 危険箇所: 排水管のS字トラップ部分。
- リスク: 逆流、高額な修理費用、悪臭の発生。
基本の捨て方1:新聞紙や古布に吸わせて可燃ゴミとして出す手順

最も安全で手軽、かつ配管トラブルのリスクがゼロなのが、この「吸わせて捨てる」方法です。特にバケツ一杯分などの大量ではない場合や、できるだけ早く片付けたい忙しい方、マンション等にお住まいで干す場所がない方に強くおすすめしています。
まず、牛乳パックやビニール袋を二重にしたものを用意してください。そこに、くしゃくしゃに丸めた新聞紙や、使い古したタオル、穴の空いた靴下、ボロボロになったTシャツなどを詰め込みます。
吸水性を高めるために、新聞紙は細かくちぎるよりも、一度クシャッと丸めてから広げたものを層にするのがコツです。ここに、ダイラタンシー液をゆっくりと注ぎ入れます。
作業のポイントは、一気に入れすぎないことです。液体が紙や布全体に行き渡るのを確認しながら、少しずつ注いでください。もし液体が多すぎて吸い切れない場合は、さらに新聞紙を追加するか、高分子吸収体を使用しているペット用トイレシートやおむつ(サイズアウトした未使用のもの等)を活用するのも非常に効果的です。
これらは水分をゼリー状に固めてくれるため、液漏れの心配が激減します。
全ての液体を吸わせたら、袋の口をしっかりと縛ります。この際、空気をできるだけ抜いてから縛ることで、ゴミの体積を減らすことができます。万が一の液漏れを防ぐため、さらに別のゴミ袋に入れて二重にしておくと安心です。
この方法は、天候に左右されず、すぐに処分を完了できるため、最も推奨されるスタンダードな手順です。
基本の捨て方2:乾燥させて粉末に戻してから処分する方法

夏場の自由研究などで、ベランダや庭など外に置いておける環境がある場合におすすめなのが「乾燥法」です。この方法は、水分の重さを完全にカットできるため、ゴミの重量を劇的に減らすことができます。
環境負荷を低減したい方や、指定ゴミ袋が有料で少しでも容量を節約したい方に適しています。
手順はシンプルです。実験で使用したトレイやバケツに入れたまま、風通しの良い日向に数日間放置します。夏場の晴天であれば、1〜2日で水分が蒸発し、カピカピに乾いた片栗粉の塊に戻ります。
ただし、この方法で注意が必要なのは「風」と「虫」です。粉末に戻りかけた状態で強風が吹くと、白い粉が周囲に飛び散り、ベランダや庭、最悪の場合はお隣の洗濯物が真っ白になってしまうことがあります。
また、甘い匂いはありませんが、食品由来のデンプンですので、アリやコバエが寄ってくる可能性も否定できません。
対策として、目の細かい洗濯ネットや不織布を容器の上にかぶせ、洗濯バサミでしっかりと固定しておくことを強くお勧めします。これにより、風による飛散と虫の侵入を同時に防ぐことができます。
完全に乾燥してひび割れた状態になったら、ヘラなどで削ぎ落とし、ビニール袋に入れて処分します。乾燥したデンプンは非常に軽いので、袋に入れる際も粉が舞い上がらないよう、静かに行うのがコツです。
時間はかかりますが、水分を含んだ重いゴミを出さずに済むという大きなメリットがあります。
- 強風: 粉が飛散し、近隣トラブルになる可能性があるためネット必須。
- 虫: 食品なのでアリなどが寄る可能性がある。
- 雨: 雨が入ると腐敗の原因になるため、天気予報を確認する。
大量にある場合の対処法と水分と固形物の分離テクニック

クラス単位のレクリエーションやイベント、または大きめのタライを使った豪快な全身実験などで、数リットル単位のダイラタンシー液が出てしまった場合、全てを新聞紙に吸わせるのは現実的ではありません。
新聞紙が大量に必要になりますし、ゴミの量が膨大になってしまうからです。このような時は、「沈殿分離法」を使って、水と固形物を分けて処理するのが賢いやり方です。
まず、容器を平らな場所に置き、絶対に揺らさずに半日〜1日ほど静置します。ダイラタンシー液は時間が経つと、比重の重いデンプン質が底に沈殿し、上澄みに透明に近い水が分離してきます。
この「完全な分離」を待つことが最大のポイントです。しっかりと層が分かれたら、容器をゆっくりと傾け、上澄みの水だけを静かに流し捨てます。この上澄み液にはデンプンがほとんど含まれていないため、排水溝に流しても詰まりの原因になることはまずありません(念のため、細かい目の排水口ネットを通すとより安心です)。
上澄みを捨てていくと、底に固く締まったセメント状のデンプンの塊が残ります。この状態になれば、水分量は大幅に減っていますので、スプーンやヘラですくい取って新聞紙に包むか、そのままビニール袋に入れて処分できます。
もし底に残ったデンプンがまだドロドロしている場合は、再度時間を置いて分離させるか、ここだけ少量の新聞紙を使って残りの水分を吸い取ってください。この「分けて捨てる」テクニックを使えば、大量の液体でも驚くほどコンパクトに、かつ安全に処分することが可能です。
自治体のゴミ分別ルールにおける片栗粉・コーンスターチの扱い

処分する準備が整ったら、最後に確認すべきは「何ゴミとして出すか」という点です。基本的には、片栗粉やコーンスターチは食品由来の物質ですので、多くの自治体では「可燃ゴミ(燃やすゴミ)」として分類されます。水分を含ませた新聞紙や布と一緒に捨てて問題ありません。
しかし、2025年現在、環境意識の高まりとともに、ゴミの分別ルールはより細分化され厳格化する傾向にあります。一部の先進的な自治体では、生ゴミや食品廃棄物を堆肥化(コンポスト)したり、バイオガス発電に利用したりする「資源循環型」の取り組みが進んでおり、食品由来の廃棄物を「資源ゴミ」や「食品循環ゴミ」として回収しているケースも増えてきています。
ただし、ダイラタンシーの実験で絵の具や食紅、ラメ、洗濯糊などを混ぜてしまった場合は注意が必要です。化学的な不純物が混ざっていると、食品リサイクルとしての処理ができず、純粋な「可燃ゴミ」としての処理が必要になる場合が多いからです。
また、水分を多く含んだゴミは焼却炉の温度を下げる原因となるため、「十分に水気を切ってください」という注意書きがある自治体も多いです。
トラブルを避けるためにも、迷った際はお住まいの自治体のゴミ分別表(アプリやWebサイト)を確認するか、ゴミ対策課などに問い合わせるのが確実です。基本原則は「水分を極力減らして可燃ゴミ」ですが、地域のルールを尊重し、適切な分別を心がけましょう。
これが、スマートな暮らしの第一歩です。
処分後の後片付けとダイラタンシーに関するよくあるトラブル解決法
- 容器や実験道具にこびりついた汚れを綺麗に落とす掃除のコツ
- 万が一排水溝に流してしまった場合の緊急対処法と業者選び
- 長期間放置してカビが生えてしまった場合の安全な処理方法
- 自由研究で使う際の注意点と実験後の保管期限について
- 次回から楽になる!後片付けを見越した実験準備のポイント
容器や実験道具にこびりついた汚れを綺麗に落とす掃除のコツ

ダイラタンシー液を捨てた後、バケツやボウルに残った白い跡。これをいきなり水でジャバジャバと洗い流そうとしていませんか?実は、それこそが排水溝詰まりの「隠れた原因」になり得ます。
容器の内側にへばりついた少量のデンプンでも、毎回の実験で蓄積すれば配管の汚れに確実に繋がります。プロが推奨する掃除の手順は、「拭き取り」ファーストです。
まず、スクレーパーや要らなくなったプラスチックカード(期限切れのポイントカードなど)を使って、容器の底や側面に残ったデンプンをこそげ落とします。乾燥して固まっている場合は、無理に剥がそうとせず、少量の水を霧吹きでかけて湿らせると、またドロドロに戻って剥がしやすくなります。
集めた汚れはティッシュで拭き取り、ゴミ箱へ捨てましょう。
大まかな汚れを取ったら、次はキッチンペーパーや古布で容器全体を丁寧に拭き上げます。白い粉っぽさがなくなるまで、しっかりと拭き取ることが重要です。この「予洗い」ならぬ「予拭き」を徹底することで、排水溝に流れるデンプンの量をほぼゼロに近づけることができます。
完全に拭き取ったことを確認してから、ようやく水洗いです。洗剤とスポンジを使って通常通り洗ってください。この時、使用したスポンジの目の中にデンプンが入り込むと、後でカチカチに固まってスポンジが使い物にならなくなることがあります。
ダイラタンシーの掃除には、使い捨てできるカットタイプのスポンジや、そのまま捨てられる古布(ウエス)を使うのが賢い選択です。道具を大切にしながら、配管も守る。このひと手間が、後片付けの質を大きく左右します。
万が一排水溝に流してしまった場合の緊急対処法と業者選び

「子供が目を離した隙に流してしまった!」「知らずに洗面所で手を洗ってしまった」——そんな時は、パニックにならずに冷静に対処しましょう。まず、絶対にやってはいけないのは、熱湯を流すことです。「熱で溶けるかも」と思われがちですが、片栗粉などのデンプンは熱を加えると糊化(こか)して粘り気が増し、強力な糊(のり)のようになって、さらに頑固な詰まりの原因になってしまいます。
緊急対処としては、まず常温の水、またはぬるま湯(40度以下)をバケツなどで「大量に、勢いよく」流すことを試みてください。まだ沈殿が始まっていない直後であれば、大量の水流による物理的な圧力で、配管の奥へと押し流せることがあります。
蛇口からチョロチョロと流すのではなく、水圧を利用するのがポイントです。それでも水の流れが悪くなったと感じたら、ラバーカップ(スッポン)を使用して物理的に圧力をかけ、詰まりを動かすのも有効です。
それでも解消しない場合は、無理にワイヤーブラシなどを突っ込まず、速やかに専門業者に依頼しましょう。デンプンによる詰まりは、油脂汚れや髪の毛の詰まりとは性質が異なり、固まるとコンクリート状になるため、市販の液体パイプクリーナーでは分解できないことが多いからです。業者を選ぶ際は、「水道局指定工事店」であるかを確認し、依頼時に「片栗粉(デンプン)を流して詰まらせた」とはっきり伝えてください。原因が明確であれば、業者も適切な機材(高圧洗浄機など)を準備でき、作業時間の短縮と費用の抑制につながります。放置すればするほど状況は悪化しますので、早めの決断が重要です。
長期間放置してカビが生えてしまった場合の安全な処理方法
「また遊ぶかも」と思って保管していたダイラタンシー液に、数日後、黒やピンクの斑点が発生してしまうことがあります。これはカビです。片栗粉は栄養価の高い炭水化物であり、水分を含んだ状態は微生物にとって絶好の繁殖環境となります。
特に梅雨時や夏場は、常温で一晩放置しただけでも腐敗が進むことがあります。
カビが生えてしまった場合、絶対に素手で触ったり、においを嗅いだりしないでください。カビの胞子を吸い込むと、アレルギー反応や呼吸器系のトラブルを引き起こす可能性があります。
処理する際は、必ずマスクとゴム手袋を着用し、換気を十分に行いましょう。
処分方法は通常のダイラタンシーと同じく「可燃ゴミ」ですが、カビの胞子が舞い散らないよう、取り扱いには細心の注意が必要です。容器ごと大きなゴミ袋に入れ、その中で新聞紙などに吸わせる作業を行うと安全です。
もし容器が安価なプラスチック製や食品用トレイであれば、中身を取り出そうとせず、容器ごと密閉して捨ててしまうのが衛生的にも精神的にもベストな選択です。「もったいない」という気持ちも分かりますが、家族の健康を守ることを最優先にしてください。
容器を再利用したい場合は、中身を捨てた後、塩素系漂白剤でしっかりと除菌・殺菌を行うことを忘れないでください。
自由研究で使う際の注意点と実験後の保管期限について

ダイラタンシーは楽しい実験ですが、「生モノの食品」を使っているという意識を持つことが大切です。基本的に、作ったその日のうちに遊びきり、その日のうちに処分するのが鉄則です。冷蔵庫に入れたとしても、分離が進んで固くなったり、雑菌が繁殖したりするため、長期保存には向きません。
自由研究で数日間にわたって観察を続けたい場合は、毎日新しく作り直すのが理想です。どうしても保存が必要なら冷蔵庫に入れ、翌日使う前に変なにおいや変色がしていないかを必ず大人が確認してください。
酸っぱいにおいや、表面に膜が張っているような状態は腐敗のサインです。直ちに廃棄してください。
また、実験を行う場所にも注意が必要です。畳やカーペットの上でダイラタンシーをこぼすと、繊維の奥に入り込んだ粒子を取り除くのは至難の業です。乾燥すると白い粉が舞い上がり、掃除機でも吸い取りきれないことがあります。
実験は、拭き掃除がしやすいフローリングの上や、お風呂場、あるいは屋外で行うのが賢明です。屋内で行う場合は、ブルーシートや大きめのゴミ袋を切り開いて敷き、その上で遊ばせることで、万が一こぼしてもシートごと丸めて捨てることができ、後片付けのストレスが激減します。
次回から楽になる!後片付けを見越した実験準備のポイント

「片付けが大変だから、もうやりたくない」となってしまうのは、非常にもったいないことです。準備の段階で少し工夫をするだけで、後片付けの手間は劇的に軽減されます。私がおすすめするのは、最初から「捨てやすい容器」で実験を行うことです。
ボウルや洗面器に直接作るのではなく、大きめの丈夫なビニール袋を二重にして、その中で水と片栗粉を混ぜる方法はいかがでしょうか?袋の口を広げてバケツやボウルにかぶせれば、安定感も確保できます。これなら、遊び終わった後は袋の口を縛るだけで、そのままゴミとして捨てることができます。容器を洗う手間も、排水溝を詰まらせるリスクも完全にゼロになります。
また、手で直接触る感触を楽しむのが醍醐味ですが、手が汚れるのを嫌がるお子様や、手洗いの際に洗面所を汚したくない場合は、薄手のゴム手袋を着用して遊ぶのも一つの手です。
これなら手洗い時の配管詰まりリスクも減らせます。「片付けまでが実験」とはよく言いますが、賢い準備で片付けのハードルを下げ、親子で心置きなく科学の不思議を楽しんでくださいね。
整活案内人総括:ダイラタンシーの捨て方は「流さない」が鉄則!排水溝を守る正しい分別と処理
この記事のまとめです。
- ダイラタンシー液を排水溝に流すと配管内で固まり詰まりの原因になる
- 詰まりは通常の洗浄では解消しにくく高額な修理費がかかるリスクがある
- 基本的な処分方法は新聞紙や古布に吸わせて可燃ゴミとして出すことである
- 乾燥させて粉末に戻してから捨てる方法はゴミの減量に効果的である
- 乾燥させる際は風で粉が飛ばないようネットなどでカバーをする
- 大量の場合は沈殿させて上澄みの水だけを捨て固形物を処理する
- 固形物は食品由来だが自治体のルールに従い適切に分別する
- 容器に残った汚れは水で洗う前に必ずスクレーパー等で拭き取る
- スポンジにデンプンが入り込むと使えなくなるため古布などを活用する
- 万が一流してしまった場合は熱湯ではなく大量の水やぬるま湯で押し流す
- カビが生えた場合は吸い込まないようマスク着用で速やかに処分する
- 実験は基本的にその日のうちに処分し長期保存は避けるべきである
- カーペットや畳の上での実験は掃除が困難になるため避ける
- ビニール袋の中で作ればそのまま捨てられて後片付けが劇的に楽になる
- 正しい知識を持つことで親子の実験遊びをより安全に楽しめるようになる










